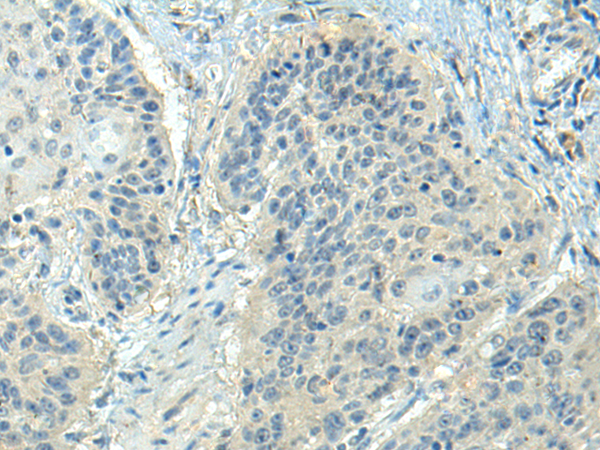
一抗

|
Background: |
The protein encoded by this gene is a secreted, extracellular matrix protein containing an Arg-Gly-Asp (RGD) motif and calcium-binding EGF-like domains. It promotes adhesion of endothelial cells through interaction of integrins and the RGD motif. It is prominently expressed in developing arteries but less so in adult vessels. However, its expression is reinduced in balloon-injured vessels and atherosclerotic lesions, notably in intimal vascular smooth muscle cells and endothelial cells. Therefore, the protein encoded by this gene may play a role in vascular development and remodeling. Defects in this gene are a cause of autosomal dominant cutis laxa, autosomal recessive cutis laxa type I (CL type I), and age-related macular degeneration type 3 (ARMD3). |
|
Applications: |
ELISA, IHC |
|
Name of antibody: |
FBLN5 |
|
Immunogen: |
Synthetic peptide of human FBLN5 |
|
Full name: |
fibulin 5 |
|
Synonyms: |
EVEC; UP50; ADCL2; ARMD3; DANCE; ARCL1A; FIBL-5; HNARMD |
|
SwissProt: |
Q9UBX5 |
|
ELISA Recommended dilution: |
5000-10000 |
|
IHC positive control: |
Human liver cancer and Human esophagus cancer |
|
IHC Recommend dilution: |
25-100 |


 購物車
購物車 幫助
幫助
 021-54845833/15800441009
021-54845833/15800441009